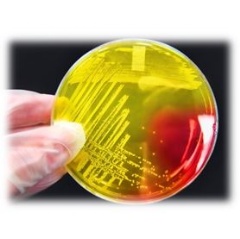

Bacterial Infection Outbreak Reported at Two Texas High Schools
Last month, KSAT published a story about 12 football players from two high schools in Texas that came down with a contagious skin infection. The culprit, impetigo, is usually caused by Staphylococcus aureus, Streptococcus pyogenes or Methicillin-resistant Staphylococcus aureus (MRSA). According to the article, the school district where the outbreak occurred had disinfected their athletic facilities as a precautionary measure.
Impetigo commonly occurs when bacteria enter the skin through cuts, scraps or insect bites. It is spread through contact with sores or mucus from the nose or throat of an infected person and is very contagious. Scratching or touching an infected area of the skin and then touching another part of the body can spread the infection.
When a person becomes infected, lesions will often appear one to three days later as red, weeping sores or blisters where the bacteria have entered the skin. The condition is fairly common in preschool and school-age children and anywhere there are crowded conditions and participation in skin-to-skin contact activities.
Although impetigo is usually easily treated, if it is caused by MRSA that changes the nature of the treatment and potential severity of the situation, said Jason Dobranic, Ph.D., Vice President of Microbiology and Life Sciences at EMSL Analytical, Inc. Many pathogens can be spread by touching contaminated surfaces and as noted in the KSAT report, the school district implemented surface disinfection procedures to try and halt the spread of this outbreak. At EMSL, we offer environmental testing services to identify the presence of bacterial pathogens on surfaces to help prevent the spread of infections. Surface testing is also important for determining if disinfection procedures are effective.
EMSL recently sponsored an educational video about Staphylococcus aureus that can be seen at: http://youtu.be/AC-dAY-DXpQ
To learn more about environmental testing for microbial pathogens or other health and safety testing services, please visit www.EMSL.com, call (800) 220-3675 or email info@EMSL.com .
About EMSL Analytical, Inc.
EMSL Analytical is a nationally recognized and locally focused provider of environmental, indoor air quality and materials testing services and products to professionals and the general public. The company has an extensive list of accreditations from leading organizations as well as state and federal regulating bodies.
( Press Release Image: https://photos.webwire.com/prmedia/9645/193307/193307-1.jpg )
WebWireID193307
- Contact Information
- Joseph Frasca
- Senior Vice President of Marketing
- EMSL Analytical, Inc.
- (1) (856) 303-2503
- Contact via E-mail
This news content may be integrated into any legitimate news gathering and publishing effort. Linking is permitted.
News Release Distribution and Press Release Distribution Services Provided by WebWire.